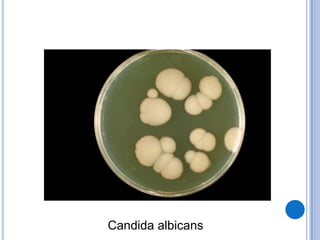
Candida albicans

O documento discute vários tipos de fungos, incluindo suas classificações, características e doenças relacionadas. É descrito que fungos podem ser simbiontes, comensais ou parasitas e que existem vários tipos como ascomicetos, basidiomicetos e oomicetos. Problemas de saúde causados por fungos como micoses e intoxicações alimentares também são abordados.